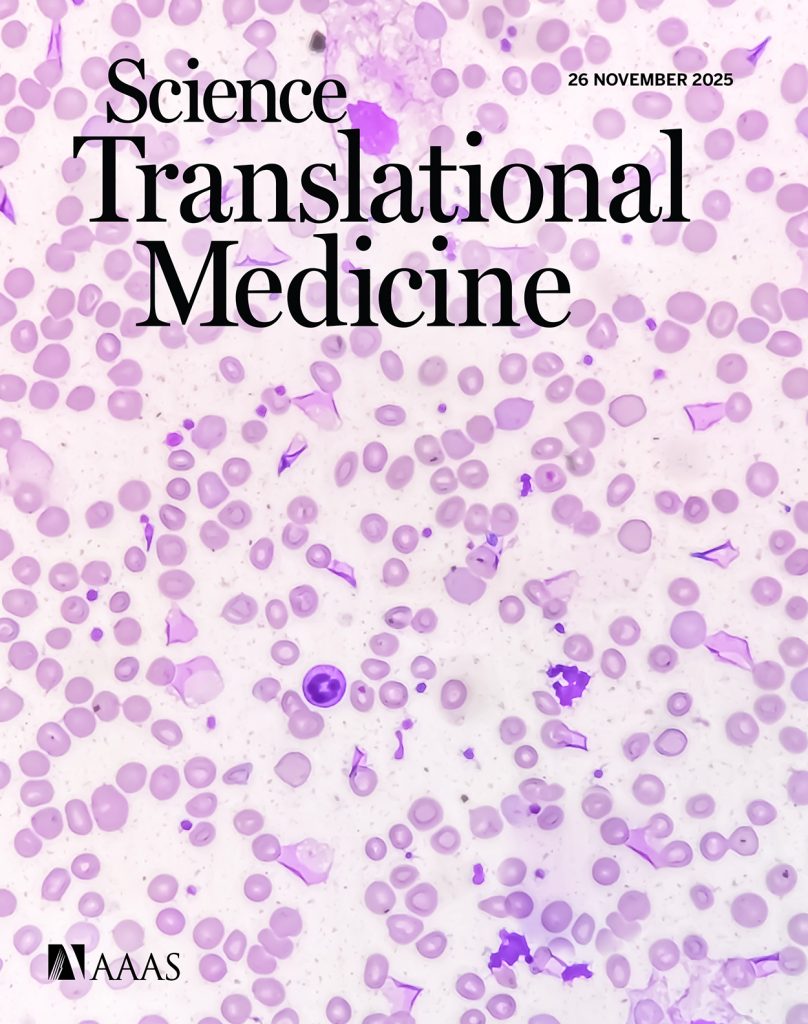

The Current Gap
Acute Myeloid Leukemia (AML) remains a challenging disease with poor long-term outcomes despite significant advancements in treatment.
While new therapies, such as FLT3 inhibitors and venetoclax-based regimens, have improved initial response rates, durable remissions and long-term survival remain elusive, particularly for older or unfit patients who cannot tolerate intensive chemotherapy or stem cell transplants ...
Our Breakthrough approach
Cycuria Therapeutics is revolutionizing blood cancer treatment with its proprietary engineered biologics.
Our approach directly and specifically targets leukemic cells and their progenitor stem cells, while preserving healthy blood formation and minimizing systemic toxicity...
High incidence rate for AML,
specially in >60 yrs population
in every 100.000
Poor Overall survival rate
for AML patients
3-year survival rate
TEAM
Our experienced management team brings deep expertise in protein engineering, clinical hemato-oncology and early-stage drug discovery and development

Dr. Nisit Khandelwal
Co-Founder & CEO

Prof. Dr. Philipp J. Jost
Inventor & Co-Founder

John Haurum
Corporate Advisor

Prof. Dr. Felix Wieland
Scientific Advisor
Our Blog
Latest CYCURIA News
Lymphotoxin alpha eradicates acute myeloid leukemia and simultaneously promotes healthy hematopoiesis in mice
Editor’s summary Relapse of acute myeloid leukemia (AML) is driven by populations of leukemic stem or progenitor cells (LSCs), which are resistant to chemotherapy. Here,

Cycuria Publishes Groundbreaking Research in Science Translational Medicine Demonstrating Lymphotoxin Alpha Eradicates Acute Myeloid Leukemia
The study, led by Cycuria’s scientific founder, Prof. Dr. Philipp Jost , a clinician-scientist, and his research team, describes a natural tumor-suppressing mechanism mediated by

Cycuria’s CEO, Dr. Nisit Khandelwal, to Present at the Upcoming BIO-Europe Conference in Vienna
Join our CEO as he presents Cycuria Therapeutics‘ latest advancements in oncology innovation at the upcoming BIO-Europe conference in Vienna . 📍 𝗕𝗜𝗢-𝗘𝘂𝗿𝗼𝗽𝗲 𝗩𝗶𝗲𝗻𝗻𝗮 🗓️
Contact Us
Cycuria Therapeutics
Center for Knowledge Transfer II (ZWT II)
Medical Science City Graz
Stiftingtalstraße 14
8010 Graz
Austria
